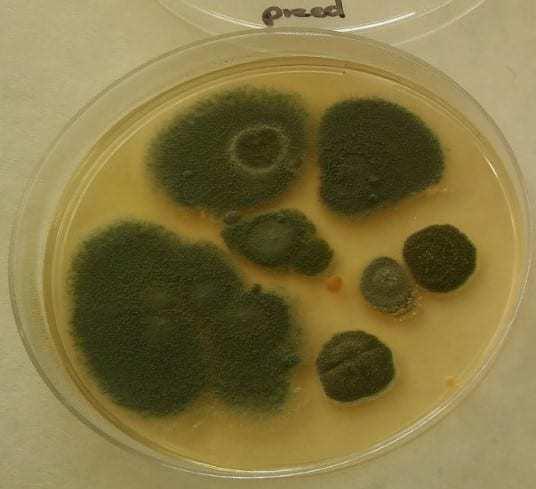
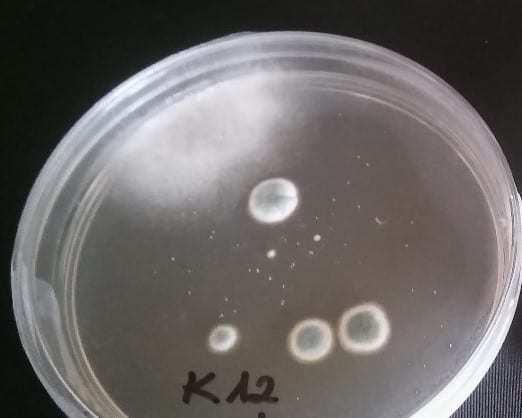

Są to średnie wyniki, które różnią się w zależności od gatunku czy technologii produkcji. Warto się pochylić nad możliwością ich redukcji, gdyż każde ograniczenie strat w czasie przechowywania i obróbki, to czysty zysk. Poniesione już bowiem zostały koszty produkcji, zbioru i przechowywania surowca.

Rys. 1. Wielkość strat owoców i warzyw w Europie na różnych etapach dystrybucji, wg UN FAO.
PRZYCZYNY POWSTAWANIA STRAT PODCZAS PRZECHOWYWANIA I PRZYGOTOWANIA DO SPRZEDAŻY
Oprócz zdrowotności zebranych warzyw i warunków przechowywania duży wpływ na wysokość strat mają infekcje wtórne zachodzące w przechowalni, czy później podczas sortowania, mycia i pakowania warzyw. Wszystkie zebrane warzywa mają mniejsze lub większe rany powstałe podczas zbioru (cięcie, oderwanie, stłuczenie, itp.) lub podczas sortowania/mycia czy polerowania. Są to miejsca, w których może dojść do infekcji wtórnych przez zarodniki grzybów czy bakterie znajdujące się na powierzchni warzyw, w powietrzu w chłodni czy w wodzie służącej do mycia lub polerowania.
Niestety w powietrzu w chłodni/przechowalni warzyw korzeniowych znajdują się zarodniki różnych rodzajów grzybów (rys. 2), z których niektóre wywołują choroby przechowalnicze. Głównie spotyka się zarodniki z rodzaju Penicillium, Alternaria, Rhizopus, Trichoderma czy Botrytis.

Rys. 2 Wyizolowane zarodniki grzybów w chłodni, gdzie przechowywane były warzywa korzeniowe – badania z pracy doktorskiej Joanny Micek z 2018/19 r.
Nieco mniej rodzajów grzybów znajduje się w przechowalniach warzyw ciepłolubnych (pomidory, papryki, ogórki) – rys. 3. Tutaj również większość stanowiły zarodniki z rodzaju Penicillium, następnie z rodzaju Alternaria, Botrytis i Sclerotinia.

Rys. 3. Wyizolowane zarodniki grzybów w chłodni, gdzie przechowywane były warzywa ciepłolubne (pomidory, papryki, ogórki) – badania z pracy doktorskiej Joanny Micek z 2018/19 r.
W trakcie przechowywania liczba zarodników grzybów, czy bakterii gnilnych w powietrzu wzrasta, gdyż rośnie liczba zainfekowanych warzyw. Czym większa liczba patogenów, tym większe mogą być straty podczas przechowywania.
NOWE MOŻLIWOŚCI OGRANICZANIA STRAT PODCZAS PRZECHOWYWANIA
Do tej pory nie było zbyt wielu dostępnych technologii (z wyjątkiem ozonowania), które by jednocześnie skutecznie ograniczały rozwój grzybów czy bakterii w trakcie przechowywania warzyw i były bezpieczne w użytkowaniu. Jednym z ostatnich odkryć jest możliwość użycia Elektro-chemicznie aktywowanej wody (ECA), zwanej wodą elektrolizowaną (EW) jako środka bakterio- i grzybobójczego. Główną substancją czynną powstałą w tym procesie jest kwas podchlorawy (HOCl). Kwas podchlorawy jest powszechnie uznawany za jeden z najskuteczniejszych znanych środków biobójczych. Jest 80-120 razy bardziej skuteczny w zwalczaniu mikroorganizmów niż np. podchloryn sodu.
Ciekawostką jest, że kwas podchlorawy jest wytwarzany naturalnie przez organizm człowieka. Kiedy nasze ciało jest atakowane przez bakterie i inne drobnoustroje, układ odpornościowy natychmiast reaguje, wysyłając leukocyty (białe krwinki) do miejsca inwazji. Leukocyty inicjują reakcję produkcji kwasu podchlorawego z wody i soli - przy pomocy impulsów nerwowych. Kwas podchlorawy jest więc środkiem biobójczym, który jest naturalnie wytwarzany przez ludzi i zwierzęta. Jest nieszkodliwy dla ludzi, zwierząt i środowiska naturalnego.
Elektrolizowana woda ECA została wprowadzona do przemysłu spożywczego, rolniczego i medycznego m.in. w Japonii, USA i Kanadzie – a ostatnio również w Europie. Jest dopuszczona do ekologicznej produkcji w Japonii i USA.
W technologii pozbiorczej elektrolizowana woda (ECA) jest coraz powszechniej stosowana na świecie do:
- Zamgławiania przechowywanych warzyw i owoców. Stosuje się mokrą mgłę w przypadku produktów wymagających wysokiej wilgotności (np. kapusta, marchew, sałata, itp.). (fot.1) W przypadku warzyw i owoców wymagających niskiej wilgotności stosuje się tak zwaną suchą mgłę wraz z gliceryną, która jest nośnikiem mgły oraz nie zwiększa wilgotności powietrza,
- Zamgławiania suchą mgłą owoców i warzyw przeznaczonych do mrożenia w celu wyeliminowania chorobotwórczych bakterii (np. Listeria), czy wirusów (np. norovirusów),
- Mycia warzyw i owoców w celu wydłużenia trwałości i poprawy bezpieczeństwa produktów. W tym przypadku stosuje się dwie możliwości:
- Dezynfekcję wody i warzyw poprzez ciągłe dozowanie ECA. Dzięki temu znacznie rzadziej stosuje się wymianę wody. Jest to również najskuteczniejsza metoda dezynfekcji warzyw, gdyż eliminowane są bakterie i grzyby z powierzchni warzyw oraz z wody. Przy tej technologii stosuje się jednak urządzenia do produkcji ECA na miejscu. Zainstalowanie takiego systemu jest kilka razy tańsze niż system ozonowania wody. Urządzenia do produkcji ECA oferuje firma Agro Smart Lab. Więcej informacji: tel. 506001551 lub email: Ten adres pocztowy jest chroniony przed spamowaniem. Aby go zobaczyć, konieczne jest włączenie w przeglądarce obsługi JavaScript.
- Dezynfekcję warzyw poprzez natrysk roztworem ECA po procesie mycia. Najczęściej używana technologia z powodu niskich kosztów stosowania.
- Mycia ciętych warzyw, sałatek i owoców w celu wyeliminowania ryzyka wystąpienia chorobotwórczych mikroorganizmów i poprawy trwałości produktu,
- Mycia warzyw i owoców przeznaczonych do przetwórstwa (kwaszenie, soki, przetwory, mrożenie),
- Przedłużenia trwałości kwiatów ciętych.
BIO ACTIW 2000 – PIERWSZY ZAREJESTROWANY ŚRODEK NA BAZIE ECA DO DEZYNFEKCJI OWOCÓW I WARZYW PO ZBIORZE
W Unii Europejskiej kwas podchlorawy powstały w wyniku elektrolizy soli i wody został oficjalnie zatwierdzony dopiero w 2018 roku. Latem 2019 roku został zarejestrowany i dopuszczony do obrotu w Polsce pierwszy środek biobójczy na bazie kwasu podchlorawego – produkt: Bio ActiW 2000, zawierający ultra czysty kwas podchlorawy. Bio ActiW 2000 jest min. dopuszczony do dezynfekcji owoców i warzyw po zbiorze (pozwolenie numer:7790/19). Produkt jest dostępny na stronie: https://sklep.agrosmartlab.com/
Badania w akredytowanym laboratorium wykazały bardzo dużą skuteczność produktu Bio ActiW 2000 w zwalczaniu bakterii, grzybów, pleśni i drożdży. Bio ActiW 2000 ma działanie typowo kontaktowe, czyli eliminuje drobnoustroje z powierzchni owoców, warzyw oraz ze ścian, opakowań i posadzki. W przypadku mycia produktów, Bio ActiW 2000 eliminuje drobnoustroje znajdujące się w wodzie oraz z powierzchni mytych owoców i warzyw.
Wstępne badania przeprowadzone przez Agro Smart Lab w magazynach i komorach chłodniczych wykazały znaczne ograniczenie występujących w powietrzu grzybów i bakterii poprzez zamgławianie przechowywanych warzyw produktem Bio ActiW 2000. Skuteczność tego zabiegu jest porównywalna z wynikami uzyskanymi poprzez ozonowanie przechowywanych warzyw (fot. 2, 3 i 4).
Przeprowadzone również wstępne badania dezynfekcji warzyw korzeniowych podczas procesu mycia i pakowania za pomocą natrysku roztworem Bio ActiW 2000 (fot. 5) potwierdziły wyniki zagranicznych doświadczeń o skuteczności ECA w wydłużeniu trwałości produktów i ograniczeniu liczby psujących się warzyw.
Bardzo interesującym zastosowaniem produktu Bio ActiW 2000 jest użycie jej do mycia ogórków przed procesem kwaszenia. Doświadczenia przeprowadzone na kilkunastu tonach mytych partenokarpicznych ogórków z użyciem Bio ActiW 2000 ( fot. 6) pozwoliło wyeliminować problem ze zbyt szybką fermentacją i pojawianiem się pustych komór w gotowym produkcie.
Wynika z tego, że Bio ActiW 2000 znacznie zredukował liczbę chorobotwórczych bakterii i grzybów znajdujących się na powierzchni, mających negatywny wpływ na proces kwaszenia, nie wpływając negatywnie na działanie bakterii kwasu mlekowego. To spowodowało, że gotowy produkt charakteryzuje się dobrymi walorami smakowymi i odpowiednią twardością ogórków.
POMIAR SKUTECZNOŚCI DEZYNFEKCJI WARZYW W PROCESIE MYCIA
Do tej pory w zasadzie nie było możliwości zmierzenia skuteczności prowadzonej dezynfekcji owoców i warzyw podczas procesu ich mycia. Od niedawna jest stosowane w przemyśle spożywczym i hodowli drobiu nowe, proste narzędzie do sprawdzania skuteczności dezynfekcji wody i wodociągów, które można z powodzeniem przenieść do ogrodnictwa. Wykorzystuje się w tym celu przenośne urządzenia do mierzenia potencjału oksydacyjno-redukcyjnego – ORP (Redox). ORP jest parametrem mierzonym w miliwoltach (mV), opisujący poziom oksydacyjny (utlenienia) wody. Wynik odzwierciedla aktywność środka odkażającego wodę, a nie poziom jego stężenia wyrażony w ppm.
Film wyjaśniający co to jest ORP (Redox) dostępny jest tutaj.
Światowa Organizacja Zdrowia (WHO) w rozporządzeniu dotyczącym standardów jakości wody pitnej ustanowiła, że na poziomie ORP równym 650 mV woda jest odkażona, a inaktywacja wirusów zachodzi prawie natychmiast. Badania wykazały, że na poziomie ORP wynoszącym 650 mV bakterie takie jak E. coli zabijane są natychmiast lub w ciągu kilku sekund . Zabicie bardziej odpornych organizmów, takich jak listeria, salmonella, drożdże i pleśnie, czy najgroźniejsze choroby bakteryjne i grzybowe roślin może wymagać ORP na poziomie 750 mV lub wyższym.
Skuteczność dezynfekcji przy pomocy wody elektrolizowanej EC jest zależne od stężenia środka, pH wody oraz twardości wody (im wyższe pH i twardsza woda - niższy poziom ORP – czyli niższa skuteczność). Najlepsza skuteczność jest przy pH: 3,0-5,5. Jednym z tańszych i bezpiecznym sposobem obniżenia pH jest zastosowanie kwasku cytrynowego (30-50 g/100 l wody).
ZASTOSOWANIE I DAWKOWANIE PRODUKTU BIO ACTIW 2000

Film wyjaśniający co to jest elektrolizowana woda obejrzysz tutaj oraz film na temat wykorzystania elektrolizowanej wody w rolnictwie w Kanadzie można zobaczyć tutaj.